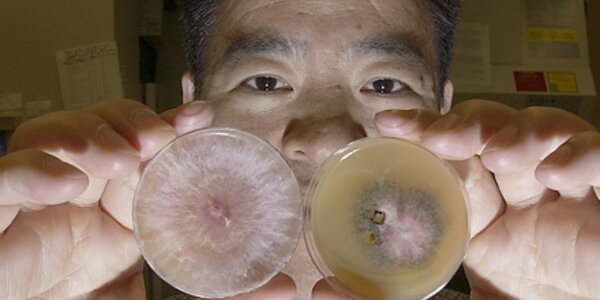
Article teaser image

Immune Disease Treatment Advance: GRP94 Protein Structure Solved
Dr. Dan Gewirth, Hauptman-Woodward senior research scientist, has just solved the structure of the first mammalian GRP94 protein implicated in immune diseases such as sepsis, AIDS and certain cancers. His work is being published today in a cover article in a top scientific journal - Molecular Cell.
Gewirth’s study confirms his 2001 hypothesis that this protein – GRP94 – is from the same family as the better known HSP90 proteins. As ligand-regulated chaperones – proteins that help other cellular proteins achieve their active shapes, the HSP90s are key players in cellular regulation and…